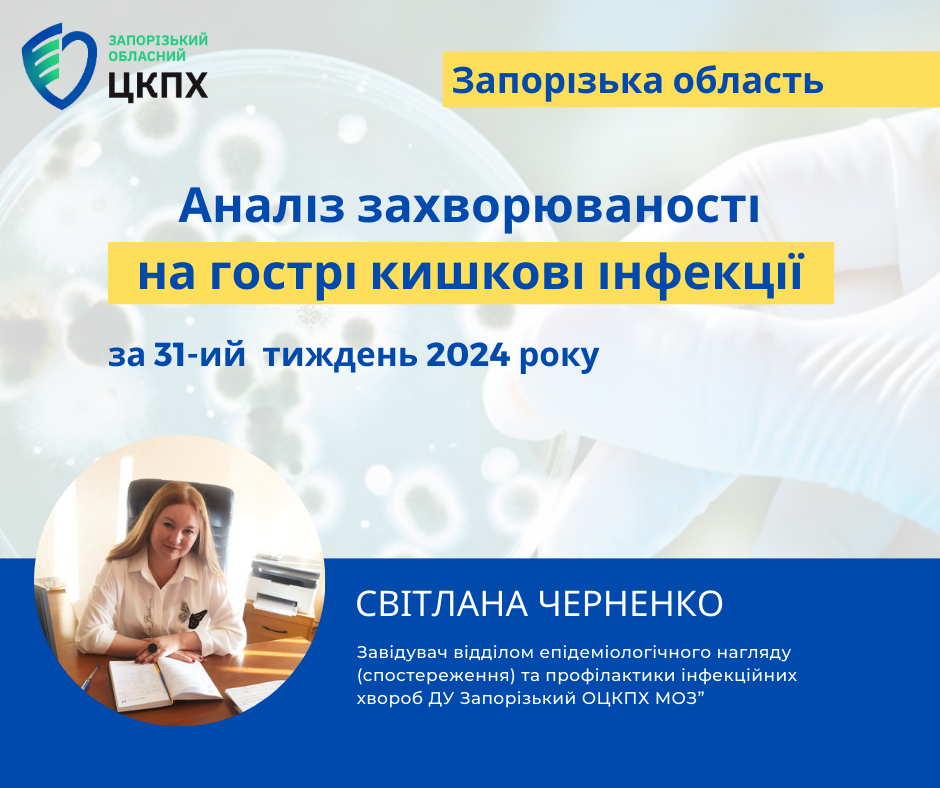

Аналіз захворюваності на гострі кишкові інфекції за 31-ий тиждень 2024 року в Запорізькій області
5 серпня 2024
Нагадуємо, що гострі кишкові інфекції — одні з найпоширеніших інфекційних захворювань, які можуть призвести до серйозних ускладнень, особливо у дітей.
За інформацією відділу епідеміологічного нагляду (спостереження) та профілактики інфекційних захворювань Запорізького обласного центру контролю та профілактики хвороб МОЗ України за період з 27.07.24 по 02.08.2024 року в Запорізькій області зареєстровано 62 випадки гострих кишкових інфекції (на двох попередніх тижнях зареєстровано 56 та 45 випадків відповідно).
Спалахів гострих кишкових інфекції не зареєстровано, випадків сальмонельозу не зареєстровано.
Захворюваність на гострі кишкові інфекції на 31 тижні зареєстрована на трьох адміністративних територіях:
– м. Запоріжжя – 56 випадків,
– Запорізький район – 5 випадків,
– Вільнянський район – 1 випадок.
Світлана Черненко, завідувач відділу епідеміологічного нагляду (спостереження) та профілактики інфекційних захворювань наголошує, що гострі кишкові інфекції — одні з найпоширеніших інфекційних захворювань, які можуть призвести до серйозних ускладнень, особливо у дітей. Зазвичай ГКІ спричинено бактеріями або вірусами, які потрапляють в організм людини із забрудненою їжею чи водою.
Також інфекція може передаваться через через брудні руки і предмети побуту, під час купання у забруднених водоймах.
Найчастіше збудники кишкових інфекцій знаходяться у сировині тваринного походження (м’ясо, яйця, непастеризоване молоко), на немитих фруктах і овочах.
Найпоширеніші симптоми гострих кишкових інфекцій — слабкість, підвищення температури, біль у животі, блювота і діарея. За перших симптомів негайно звертайтеся до лікаря!
Щоб уберегтися від харчових отруєнь і гострих кишкових інфекцій, вживайте лише ті продукти, у якості яких ви впевнені, дотримуйтеся 5 кроків до безпечнішої їжі.
5 кроків до безпечнішої їжі
- Підтримуйте чистоту:
- мийте руки перед тим, як брати продукти чи готувати їжу;
- мийте руки після відвідування туалету;
- вимийте і продезінфікуйте всі поверхні та кухонне приладдя, які використовуєте для приготування їжі;
- захищайте кухню і продукти від комах, гризунів та інших тварин.
- Відокремлюйте сиру їжу від готової:
- відокремлюйте сиру продукцию від інших харчових продуктів;
- для обробки сирих продуктів користуйтеся окремим кухонним приладдям, зокрема ножами і обробними дошками;
- зберігайте продукти у закритому посуді, щоб уникнути контакту між сирими і готовими продуктами.
- Ретельно готуйте їжу:
- ретельно просмажуйте чи проварюйте продукти, особливо м’ясо, яйця і морепродукти;
- доводьте страви до кипіння, щоб вони готувалися щонайменше за 70 °С;
- сік м’яса чи птиці під час приготування має бути прозорим, а не рожевим;
- ретельно підігрівайте приготовану їжу.
- Зберігайте їжу при безпечній температурі:
- не залишайте приготовану їжу за кімнатної температури більш ніж на 2 години;
- не зберігайте їжу надто довго, навіть у холодильнику;
- не розморожуйте продукти за кімнатної температури.
- Використовуйте безпечну воду і свіжі продукти:
- використовуйте чисту або очищену воду;
- обирайте свіжі та незіпсовані продукти;
- ретельно мийте овочі й фрукти, особливо якщо вживатимете їх сирими;
- не вживайте продукти, у яких закінчився термін придатності.
Віруси чи бактерії можуть потрапити в харчові продукти на будь-якій стадії шляху від виробництва до столу, тому кожен учасник процесу, від виробника до споживача, відіграє роль у запобіганні зараженні їжі.


